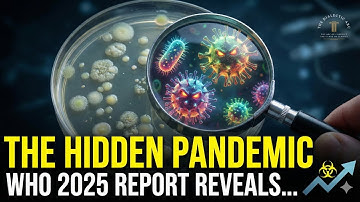
1 in 6 Infections Now Untreatable | WHO Proves Antibiotic Resistance

⬇ DOWNLOAD NOW
Kalau muncul iklan pop-up, tutup lalu klik tombol kembali
Download lagu Why Do Pandemics Change The Labor Force Participation Rate? - Demographic Data Answers secara gratis hanya untuk keperluan promosi. Dukung artis favorit kamu dengan membeli musik original di iTunes atau platform resmi lainnya.
 How Do Pandemics Change Employment Data? - Demographic Data Answers
How Do Pandemics Change Employment Data? - Demographic Data Answers
 How Did Women's Labor Force Participation Rate Change? - Demographic Data Answers
How Did Women's Labor Force Participation Rate Change? - Demographic Data Answers
 How Do Cyclical And Structural Changes Impact The Labor Force Participation Rate?
How Do Cyclical And Structural Changes Impact The Labor Force Participation Rate?
 Why Did Female Labor Force Participation Shift Over Time? - Demographic Data Answers
Why Did Female Labor Force Participation Shift Over Time? - Demographic Data Answers
 What Caused The Dramatic Rise Of Women In The Labor Force? - Demographic Data Answers
What Caused The Dramatic Rise Of Women In The Labor Force? - Demographic Data Answers
 How Do Pandemics Get Around the World?
How Do Pandemics Get Around the World?
 How Did COVID-19 Affect Retail Sales and Employment? | #LetsFREDthat
How Did COVID-19 Affect Retail Sales and Employment? | #LetsFREDthat
1 in 6 Infections Now Untreatable | WHO Proves Antibiotic Resistance
1 in 6 Infections Now Untreatable | WHO Proves Antibiotic Resistance